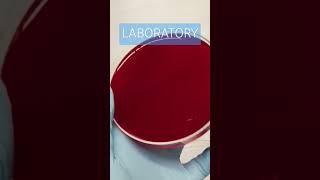

Shared 1 year ago
5.1K views
Shared 9 months ago
2.4K views
My everyday job as a medical technologist #laboratory #mls #cls #medtechstudent #laboratorylife #rmt
Shared 2 years ago
4.1K views
Shared 1 year ago
94 views
Shared 1 year ago
2.3K views
Daily life inside the Laboratory #medtechlife #laboratorylife #blood #electrolytes #mls #cls #medtec
Shared 1 year ago
1.1K views
Shared 1 year ago
3.3K views
Shared 1 year ago
400 views
Shared 11 months ago
88 views
Shared 1 year ago
1.6K views
Shared 1 year ago
2.3K views
Daly Life inside the Laboratory Day 01 #laboratory #mls #medtechstudent #medtechlife #laboratorylife
Shared 1 year ago
597 views
Shared 1 year ago
6.6K views
Shared 1 year ago
3.7K views
Shared 1 year ago
733 views
The Medtech Life #mls #cls #medtechstudent #medtech #laboratory #medicaltechnologist #laboratorylife
Shared 2 years ago
629 views
Shared 1 year ago
532 views
Lab Technician 🧪Life 🧬#viralvideo #labtechnician #bloodtest#laboratorylife #shortvideo #Dscvlogs2025
Shared 1 year ago
321 views
Shared 2 years ago
17 views
Shared 1 year ago
357 views
Shared 1 year ago
266 views
Shared 1 year ago
187 views
Shared 1 year ago
512 views
Shared 1 year ago
693 views
Shared 1 year ago
1.2K views
Shared 1 year ago
429 views
Shared 11 months ago
123K views
Shared 1 year ago
1.3K views
Shared 1 year ago
459 views
Shared 1 year ago
588 views
Shared 1 year ago
1.4K views
Shared 1 year ago
433 views
Shared 1 year ago
554 views
Shared 1 year ago
5.8K views
Shared 1 year ago
499 views